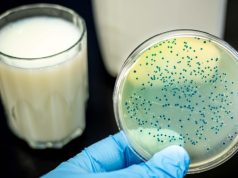

TÜRKİYE’DE BRUSELLOZ MEVCUT DURUM RAPORU
Current Situation Report of Brucellosis in Türkiye
Rapor için tıklayınız
TÜRKİYE’DE TULAREMİ MEVCUT DURUM RAPORU
Current Situation Report of Tularemia in Türkiye
Rapor için tıklayınız
Please follow and like us: